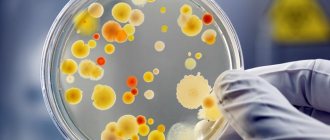
Причины повышенного антистрептолизина О

Лаборатория
Общий анализ крови — это обязательная диагностическая процедура, которую проходит каждый человек, обратившийся к
Белые кровяные тельца или лейкоциты сами по себе неоднородны. Это общее наименование пяти структур.
Что такое АФП – онкомаркер? Онкомаркеры – это своеобразные клетки белкового вида, являющиеся ответной
Понятие об АЧТВ Показатель АЧТВ характеризует внутренний путь свертывания Активированным частичным тромбопластиновым временем называется
Что представляет собой анализ крови МНО МНО – не является фактической величиной, и вычисляется
Показания для изучения АСЛ-О Бета-гемолитический стрептококк – это шарообразная бактерия, которая вызывает фарингит, ангину,
Эозинофилы принято считать маркерами паразитарных инвазий и аллергических реакций. Повышение их уровня называется эозинофилией.
По своей сущности кровь является жидкостью, обеспечивающую работоспособность и жизнь организма. Кровь состоит из
Что такое HBsAg? HBsAg — это особое белковое соединение, которое является поверхностной оболочкой вирусных
ЛПНП (LDL) – что это такое в биохимическом анализе крови? ЛПНП / LDL (или